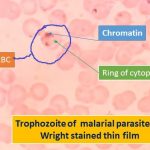
Trophozoite of Malarial parasite

Collection Group: Medical Parasitology
Wuchereria bancrofti Microfilaria in Methylene Blue Preparation and Filariasis in Details
 Microfilaria of Wuchereria bancrofti in methylene blue preparation Microfilaria of...
Microfilaria of Wuchereria bancrofti in methylene blue preparation Microfilaria of...
Gametocyte of Plasmodium falciparum and Details about Malarial Parasites
 Gametocyte of Plasmodium falciparum Gametocyte of plasmodium falciparum showing the...
Gametocyte of Plasmodium falciparum Gametocyte of plasmodium falciparum showing the...
Trophozoite of Malarial parasite and Its Details
Trophozoite of Malarial parasite Trophozoite of Malarial parasite having chromatin...
Trophozoite of Malarial parasite Trophozoite of Malarial parasite having chromatin...
